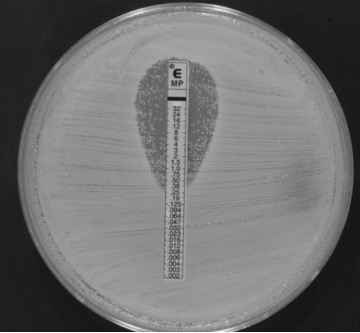
Carbapenem_E-test

This is a not so infrequent meropenem E-test of a carbapenemase-producing K. pneumoniae (OXA-48). There is a well-defined halo around the stripe but as it can be easily seen, there are colonies within the halo.
.
- What do these inside-the-halo colonies mean?
- Are these colonies resistant to meropenem?
- Mutant, heteroresistant strains or simply an artifact?
- How should MIC be read?
.
Comments are welcome!!!!